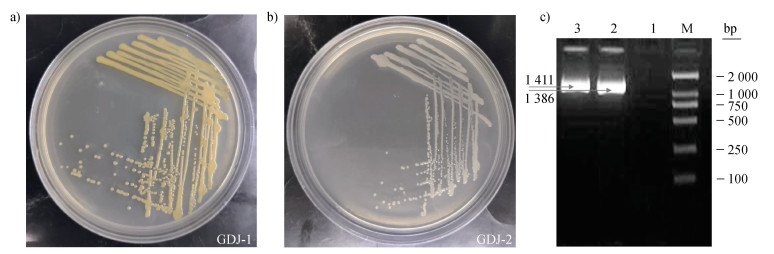

2. 三峡大学水泥基生态修复技术湖北省工程研究中心, 湖北宜昌 443000;
3. 中国科学院山地灾害与地表过程重点实验室, 成都 610041;
4. 武汉市汉阳市政建设集团有限公司, 武汉 430000;
5. 三峡大学防灾减灾湖北省重点实验室, 湖北宜昌 443000
2. Hubei Provincial Engineering Research Center of Slope Habitat Construction Technique Using Cement-based Materials, China Three Gorges University, Yichang, Hubei 443000, China;
3. Key Laboratory of Mountain Hazards and Surface Processes, Chinese Academy of Sciences, Chengdu 610041, China;
4. Wuhan Hanyang Municipal Construction Group Co.Ltd, Wuhan 430000, China;
5. Hubei Key Laboratory of Disaster Prevention and Mitigation, China Three Gorges University, Yichang, Hubei 443000, China
植被混凝土生态修复技术是工程扰动区裸露陡边坡植被恢复的有效措施之一,已被广泛应用于矿山、交通、水利受损边坡的生态修复[1]。目前植被混凝土生态修复技术在气候温和地区的实践效果较好[2],但冻融区应用情况尚有待提升。例如,三峡大学边坡生态修复研究团队通过对双江口、两河口水电站等多个冻融区植被混凝土样地进行了持续监测,发现竣工后数年内植被盖度及多样性明显降低。通过试验表明,冻融环境下植被混凝土基材肥力可持续性降低导致植被逐步退化是造成冻融区生态护坡工程修复效果欠佳的主要原因,而反复的冻融还会使部分微生物进入休眠状态甚至死亡则是根本原因之一。
边坡生态修复过程中,生态基材养分状况的恶化通常是导致修复效果衰退的主因[3]。虽然人工施肥能在短期内提升基材养分含量和微生物活性,但对基材长期肥力维持和生态系统健康恢复并无持久改善效果[4]。相比之下,施用功能微生物菌剂或菌肥,可有效提高和维持基材肥力[5]。然而,施用菌肥或菌剂的实际效果会因土壤环境条件及菌种特性而异,在选择菌剂时需充分考虑其适应性和功能性。由于自生固氮菌具有较强的固氮能力,可为植物提供必须的氮素营养,促进植物生长发育,故广泛应用于微生物菌剂的研制[6]。此外,植被混凝土由于水泥成分的掺入可能导致微生物活性受到抑制,不同微生物对碱性环境的耐受性差异明显[7]。因此,优先选用具有较强适应性的土著微生物显得尤为关键。同时,菌种对气候环境的耐受力也是筛选优势菌种时的重要因素,目前针对冻融作用下的土壤微生物研究,关注点主要集中在冻融作用对微生物数量[8]、群落结构[9]以及胞外酶活性[10]的影响等方面。对于能够在冻融条件下存活并具优势的本土菌种重新引入土壤后,其对土壤理化性质以及植物生长产生的影响有待进一步研究。综上所述,在应用菌剂或者菌肥提升植被混凝土在冻融区的修复效果时,从植被混凝土中筛选出能够适应多次冻融循环且具有良好固氮能力的土著固氮菌至关重要。
鉴于此,本文以植被混凝土为研究对象,通过开展冻融模拟试验,研究其在不同冻融温度与冻融次数条件下固氮微生物数量的变化规律;再筛选出冻融耐受性强、具有高效固氮特性的自生固氮菌,并对其进行菌种鉴定;最后依据鉴定结果将菌株扩大培养制备成菌液,采用种子萌发试验和盆栽试验,研究菌液对黑麦草种子萌发、生长以及植被混凝土理化性质的影响。以期为制备适用于冻融地区的功能微生物菌剂提供理论依据,为植被混凝土生态修复技术在冻融地区的应用提供技术支撑。
1 材料与方法 1.1 供试材料制备植被混凝土所涉及的主要材料包括种植土壤、水泥、有机物料、生境基材改良剂、水。种植土壤选用黄棕壤土,取自宜昌市周边地区,经自然风干后过2 mm筛备用。水泥采用华新水泥(宜昌)有限公司生产的P.O 42.5普通硅酸盐水泥。有机物料采用夜明珠华鑫木材厂提供的锯末,经风干后过2 mm筛备用。生境基材改良剂由湖北润智生态科技股份有限公司提供(专利号:01138343.7)。试样制备时,参照现行能源行业标准《水电工程陡边坡植被混凝土生态修复技术规范》(NB/T 35082—2016)[11],各组分质量比为种植土:水泥:有机物料:生境基材改良剂:水=100︰6︰4︰3︰34。
1.2 冻融条件下自生固氮菌的分离筛选方法 1.2.1 冻融循环采用环刀(直径为100 mm,高度为100 mm)制备植被混凝土试样。制备完成后用保鲜膜密封,再置于标准养护室(温度20±2 ℃、相对湿度95%),养护60 d。养护完成后,将试样放入冻融试验箱(XT5405G-FSC型,雪中炭恒温技术有限公司,杭州)中,采用“气冻-气融”模拟冻融环境。设置F1(–10 ℃/10 ℃)和F2(–20 ℃/20 ℃)两种冻融模式,并定义冻结12 h、融化12 h为1次冻融循环。分别在0、1、2、5、10、15、20次循环后使用稀释平板计数法测定固氮微生物的数量。
1.2.2 分离与筛选采用Ashby无氮固体培养基用于固氮微生物的分离、纯化,其组分包括甘露醇10 g、磷酸二氢钾0.2 g、硫酸镁0.2 g、氯化钠0.2 g、硫酸钙0.2 g、碳酸钙5 g、琼脂15 g、蒸馏水1 000 mL。培养、鉴定纯化的固氮菌采用LB(Luria-Bertani)培养基,其组分包括胰蛋白胨10 g、酵母浸粉5 g、氯化钠10 g、蒸馏水1 000 mL。取20次冻融后的植被混凝土试样,制得稀释度分别为10–1、10–2、10–3、10–4、10–5和10–6的菌悬液,置于30 ℃的恒温培养箱中培养48 h。将培养后的菌液涂布于无氮培养基平板上,倒置培养至出现明显菌落,每个梯度3个重复,挑取单一菌落多次划线纯化保存备用。将分离出的菌落接种至三角瓶中培养10 d后,用比浊法(OD600值)比较各菌株生长量的差异。采用微量凯氏定氮法测定菌液的含氮量,根据结果筛选出固氮能力强的菌种。
1.3 自生固氮菌的鉴定方法 1.3.1 形态学观察与生理生化试验用革兰氏染色法对菌体细胞染色,在光学显微镜下观察其形态特征。参照《常见细菌系统鉴定手册》[12]、《微生物学实验》[13]对固氮菌株的生理生化特征进行测定与分析,试验主要测定:氧化酶、过氧化氢酶、脲酶、硝酸还原酶、甲基红试验(MR)、Voges-Proskauer试验(V-P)、明胶液化反应、淀粉水解反应、吲哚试验、油脂水解、产硫化氢试验、丙二酸盐、柠檬酸盐、含碳化合物的利用试验。
1.3.2 分子生物学鉴定提取试验固氮菌的DNA片段作为模板,以16S rDNA全序列通用引物27F/1942R进行PCR扩增,16S rDNA全序列扩增条件:94 ℃预变性5 min;94 ℃变性30 s,57 ℃退火30 s,72 ℃延伸90 s,25个循环;72 ℃延伸7 min。取2 μL的PCR产物,用2%的琼脂糖凝胶电泳进行产物验证。将扩增产物送至北京睿博兴科生物技术有限公司进行测定,将测序结果与美国国家生物技术信息中心(NCBI)数据库进行比对。
1.4 菌株生长曲线和环境适应性试验 1.4.1 菌株生长曲线将分离出的自生固氮菌在无氮培养基中培养24 h,用无菌接种环挑取菌株至培养基中,培养24 h,用移液枪接种至液体LB培养基中,进行恒温摇床培养。每2小时吸取2 mL的菌液,以无菌的LB液体培养基作空白对照,测定其在600 nm处的吸光值。记录菌株生长的时间及相应的OD600值,每个样品3次重复取其平均值,绘制出固氮菌的生长曲线。
1.4.2 环境适应性试验酸碱度试验:用无菌接种环挑取固氮菌的单菌落至Ashby液体培养基中,置于30 ℃,180 r·min–1摇床中培养24 h后,按1%的接种量,用移液枪吸取2 mL固氮菌菌液,转接至pH为4、5、7、9、11的摇瓶(250 mL培养基)中,培养12 h,采用紫外分光光度计(UV-1800型,岛津,日本)测定菌悬液的OD600吸光值,重复3次。渗透压试验:用移液枪吸取2 mL固氮菌液置于不同NaCl质量分数浓度(0.5%、1%、2%、3%、4%、5%)的LB液体培养基中,培养12 h(30 ℃,180 r·min–1)后测定菌悬液的OD600吸光值。
1.5 自生固氮菌的促生试验 1.5.1 黑麦草种子萌发试验选用生态护坡常用植物黑麦草(品种:冬牧70)进行自生固氮菌促生试验,所需种子购自江苏鑫瑞种业有限公司。将黑麦草种子放入无菌培养皿(放双层滤纸),每皿30粒均匀摆放。保证滤纸紧贴皿底,用蒸馏水润湿种子放入皿中。试验组加入分离后扩繁的菌液,对照组设置等量蒸馏水。放入光照培养箱中培养,参数设置为25 ℃恒温,光照12 h,黑暗12 h。待幼芽达到粒长的二分之一后,每隔24 h记录1次发芽状况。第5天计算发芽势,第10天计算发芽率。种子发芽势、发芽率计算公式为:发芽势=(第5天已发芽的种子总数/试验种子总数)×100%,发芽率=(已发芽的种子总数/试验的种子总数)×100%。在第10天时,每组随机选取5株幼苗测定苗高和根长。
1.5.2 黑麦草盆栽试验设置3组盆栽种植试验:CK(未施用菌液)、GDJ-1(施用GDJ-1菌液,GDJ-1为2.2小节分离的自生固氮菌)、GDJ-2(施用GDJ-2菌液,GDJ-2为2.2小节分离的自生固氮菌),每组设3个平行样。盆栽规格为盆口直径21 cm、盆底直径15 cm、高19 cm,聚丙烯树脂材质。每盆播30粒种子,出苗15 d后间苗。两组菌液的施用量均为100 mL,接种浓度为107 CFU·mL–1。试验时间为2022年12月22日至2023年3月31日,间隔100 d,地点为宜昌市五峰镇某试验场地(30°12′2′′N,110°40′15′′E)。根据中国气象数据网五峰站数据(https://data.cma.cn/),试验期间气温数据如图 1所示。试验阶段前30 d每天早晚各浇水100 mL,其他时间根据天气状况及黑麦草生长情况适当浇水。100 d后每盆随机选取10株黑麦草测定其株高并计算平均值。采用直接收割法测定每盆植株的地上生物量,用挖掘收获法测定植株地下生物量。取种植盆中的植被混凝土测定pH(电极法)、容重(环刀法)、有机质(重铬酸钾外加热法)、碱解氮(碱解扩散法)、全氮(凯氏定氮法)、有效磷(紫外分光光度计法)和速效钾(原子吸收分光光度计法)。

|
注:数据来源于中国气象数据网五峰站数据(https://data.cma.cn/)。虚线表示当天最高气温大于0℃、最低气温小于0℃,盆栽经历一次冻融循环。 Note: The data are from Wufeng Station of China Meteorological Data Service Centre (https://data.cma.cn/). The dashed line indicates that the highest temperature on the day is greater than 0 ℃, the lowest temperature is less than 0 ℃, and the pot undergoes a freeze-thaw cycle. 图 1 试验期间的气温 Fig. 1 Air temperature during the experiment |
使用Excel 2016进行数据处理,SPSS 19.0进行相关性分析,运用MEGA 7.0软件的邻接法构建系统发育树。
2 结果 2.1 冻融条件下自生固氮菌的分离筛选 2.1.1 冻融条件下固氮微生物数量变化图 2显示,在两种冻融模式(F1、F2)下植被混凝土中固氮微生物数量分布范围分别为4.67×108~11.23× 108 CFU·g–1、3.57×108~11.10×108 CFU·g–1。随冻融循环次数的增加,不同冻融模式下固氮微生物数量均呈先下降后略微上升再下降的趋势。冻融初期固氮微生物急剧减少,冻融循环5次时降低至最小值,此时植被混凝土中固氮微生物数量较未冻融时分别降低了58.41%、67.84%;20次冻融循环结束后,分别降低了53.10%、65.16%。

|
注:F1、F2为两种冻融模式,F1为–10 ℃至10 ℃,F2为–20 ℃至20 ℃。 Note: F1 and F2 represent two freeze-thaw modes, F1 is –10 ℃ to 10 ℃, F2 is –20 ℃ to 20 ℃. 图 2 两种冻融模式(F1、F2)下固氮微生物的数量变化 Fig. 2 Changes in the number of nitrogen-fixing microorganisms under two freeze-thaw modes (F1, F2) |
F2模式下植被混凝土中固氮微生物数量降幅大于F1模式,在20次冻融循环时,F2模式下的固氮微生物较F1模式降低26.58%,表明冻融温差对于植被混凝土中固氮微生物生存影响更显著。因此,选取F2模式下冻融20次的植被混凝土试样分离自生固氮菌,以保证分离出来的固氮菌具有较强的耐冻融性。
2.1.2 固氮菌株分离筛选采用F2模式从植被混凝土中分离出四株自生固氮菌并将其命名为GDJ-1、GDJ-2、GDJ-3、GDJ-4,对分离出的固氮菌进行OD600值和固氮能力测试。结果表明,GDJ-1、GDJ-2、GDJ-3、GDJ-4的OD600值分别为0.349、0.458、0.125、0.101,固氮量分别为2.84、3.22、1.12、1.28 mg·L–1。GDJ-1与GDJ-2的生长量较高,固氮能力较强,而GDJ-3、GDJ-4的生长量与固氮量均低于GDJ-1与GDJ-2。根据试验结果,选用GDJ-1与GDJ-2作为后续扩大培养和试验的菌种。
2.2 菌株的鉴定 2.2.1 菌株的形态学特征分离纯化后对两种菌株的形态进行观察,GDJ-1的形态学特征可描述为(图 3a):黄色,光滑,不透明,圆形,稍隆起,边缘整齐,革兰氏染色为阳性;GDJ-2的形态学特征可描述为(图 3b):米色,光滑,不透明,圆形,稍隆起,边缘整齐,革兰氏染色为阴性。两种菌株的形态学特征存在较大差异,主要表现在颜色的区别以及对革兰氏染色的反应上。革兰氏染色的不同揭示了两种菌株在细胞壁结构与组成上存在差异。
2.2.2 菌株的生理生化特征表 1显示,两种菌株的生理生化特性存在差异,GDJ-1不产氧化酶但产过氧化氢酶、不具备分解明胶和水解淀粉的能力,而GDJ-2产氧化酶但不产过氧化氢酶,具备分解明胶和水解淀粉的能力。
|
注:M:DNA分子质量标准;1:阴性对照;2:GDI-1菌株;3:GDJ-2菌株。 Note: M: DNA molecular quality standard; 1:negative control; 2:GDI-1 strain; 3:GDJ-2 strain. 图 3 菌落形态特征与PCR扩增结果 Fig. 3 The colony morphological characteristics of strains GDJ-1 (a), GDJ-2 (b) and their PCR amplification results (c) |
|
|
表 1 自生固氮菌GDJ-1与GDJ-2的生理生化特征 Table 1 Physiological and biochemical characteristics of two autotrophic nitrogen-fixing bacteria GDJ-1 and GDJ-2 |
如图 3c所示,GDJ-1与GDJ-2通过通用引物27F/1942R分别扩增出1 386 bp、1 411 bp的目的条带。
通过基本局部比对搜索工具(BLAST)序列比对结果构建GDJ-1与GDJ-2的16S rDNA序列系统发育进化树结果如图 4所示。固氮菌GDJ-1属于微杆菌属分支并且与Microbacterium proteolyticum strain RZ36(GenBank登录号NR 135869.1)序列的相似度达99.13%,固氮菌GDJ-2属于罗尔斯顿属分支并且与Ralstonia pickettii strain NBRC 102503(GenBank登录号NR 114126.1)序列的相似度达99.93%。综合形态学特征、生理生化反应和16S rDNA序列系统发育结果,将GDJ-1菌株鉴定为蛋白水解微杆菌(Microbacterium proteolyticum strain RZ36),命名为(Microbacterium proteolyticum sp. GDJ-1)。将GDJ-2菌株鉴定为皮氏罗尔斯顿菌(Ralstonia pickettii strain NBRC 102503),并命名为(Ralstonia pickettii sp. GDJ-2)。

|
注:分支处数字表示1 000次自助抽样分析的支持百分比,标尺0.0020表示进化距离。 Note: The number at the branch represents the percentage of support for 1 000 bootstrap resampling analyses, and the scale 0.0020 represents the evolutionary distance. 图 4 基于16S rDNA序列的GDJ-1(a)和GDJ-2(b)菌株系统发育进化树(N-J法) Fig. 4 Phylogenetic tree of GDJ-1 strain (a) and GDJ-2 strain (b) based on 16S rDNA sequence (N-J method) |
有研究表明,蛋白水解微杆菌最早由Alves等[14]在海马齿苋根际中分离,其形态学特征、生理生化特征、基因测序结果并不同于亲缘物种,是一种新的微杆菌属。皮氏罗尔斯顿菌是一种广泛存在于土壤中的微生物,既是人类的致病菌也可感染部分植物[15-16]。同时,皮氏罗尔斯顿菌还具有降解甲苯、三氯乙烯等多种有害物质的能力[17]。
2.3 菌株的生长曲线与环境适应性 2.3.1 菌株生长曲线如图 5所示,GDJ-1在0~6 h生长迟缓,6~18 h呈对数生长,18~24 h处于稳定期。GDJ-2在0~4 h生长迟缓,于4~16 h进入快速生长的对数期,16~24 h处于稳定期。

|
图 5 自生固氮菌GDJ-1与GDJ-2的生长曲线 Fig. 5 Growth curves of autotrophic nitrogen-fixing bacteria GDJ-1 and GDJ-2 |
如图 6a所示,菌株GDJ-1与GDJ-2均可在5个pH水平梯度下生长,其生长量(OD600)分布范围分别为0.218~1.111、0.287~1.230,表明两种固氮菌株pH生长范围较广,对酸碱度有较强的适应性。在pH为4~9时,GDJ-1与GDJ-2的OD600值随pH的增大而增大。在pH为9~11时,随着pH的增大两种自生固氮菌的OD600值逐渐减小。此外,在5个pH梯度下GDJ-2的OD600值均高于GDJ-1,表明GDJ-2对酸碱度的耐受性优于GDJ-1。

|
注:不同小写字母表示同一种自生固氮菌不同pH或NaCl质量分数间差异显著(P < 0.05),不同大写字母表示同一pH或NaCl质量分数条件下不同自生固氮菌间差异显著(P < 0.05)。 Note: Different lowercase letters indicate significant differences among different pH or the NaCl mass fraction for the same autotrophic nitrogen-fixing bacteria (P < 0.05), while different capital letters indicate significant differences between two kinds of autotrophic nitrogen-fixing bacteria at the same pH or the NaCl mass fraction (P < 0.05). 图 6 pH(a)和渗透压(b)对自生固氮菌GDJ-1与GDJ-2生长的影响 Fig. 6 Effects of pH (a) and osmotic pressure (b) on the growth of autotrophic nitrogen-fixing bacteria GDJ-1 and GDJ-2. |
图 6b显示,GDJ-1与GDJ-2在6种NaCl浓度下的吸光值(OD600)分布范围分别是0.227~1.011、0.128~1.112。随着NaCl浓度增大,GDJ-1与GDJ-2的OD600值逐渐下降。在5% NaCl浓度下,二者的OD600值下降至最低,说明渗透压的增大会抑制两种自生固氮菌的生长,过高的渗透压使菌株繁殖能力大幅下降。此外,两种自生固氮菌对于渗透压的适应性有差异。在0.5%、1%、2% NaCl浓度下,GDJ-2的OD600值高于GDJ-1,在3%、4%、5% NaCl浓度下,GDJ-1的OD600值高于GDJ-2。
2.4 菌株对植被混凝土理化指标的影响 2.4.1 理化性质变化表 2结果显示,经过菌液处理的试验组GDJ-1与GDJ-2的pH分别为7.91、8.06,较对照组均有不同程度的降低。施用GDJ-1与GDJ-2菌液后,植被混凝土有机质含量较对照组分别增加了5.74%、3.04%,全氮含量较对照组分别增加了22.31%、21.79%,碱解氮含量较对照组分别增加了62.95%、12.43%,有效磷含量较对照组分别增加了53.67%、35.73%,速效钾含量变化不明显。可见,施用GDJ-1与GDJ-2菌液均可有效提升植被混凝土肥力水平,其中GDJ-1对碱解氮和有效磷的提升幅度可达62.95%和53.67%。
|
|
表 2 自生固氮菌GDJ-1与GDJ-2对植被混凝土理化性质的影响 Table 2 Effects of autotrophic nitrogen-fixing bacteria GDJ-1 and GDJ-2 on the physical and chemical properties of vegetation concrete |
植被混凝土理化指标的相关性分析如图 7a所示,pH与有机质、全氮、碱解氮、有效磷、速效钾呈负相关性,其中与有效磷呈显著负相关(P < 0.05)。容重与有机质、全氮、碱解氮、有效磷呈负相关关系,与速效钾呈正相关关系。有机质则与全氮、碱解氮、有效磷、速效钾均呈正相关。在养分指标间,全氮与碱解氮、有效磷呈正相关关系,而与速效钾呈负相关关系。

|
注:“*”表示显著相关(P < 0.05)。不同小写字母表示不同处理方式间差异显著(P < 0.05)。 Note: "*" indicates a significant correlation (P < 0.05). Different lowercase letters indicate significant differences among different treatments (P < 0.05). 图 7 植被混凝土理化性质指标相关性(a)、黑麦草的发芽率/发芽势和苗高/根长(b) Fig. 7 Correlation analysis of physical and chemical properties of vegetation concrete (a), germination rate, potential, seedling height and root length of ryegrass (b) |
图 7b显示,经过自生固氮菌GDJ-1与GDJ-2菌液处理后,黑麦草种子的发芽势高于对照组。其中,经过GDJ-2菌液处理的黑麦草种子的发芽势达到68.89%,较对照组提高了13.33%。GDJ-1与GDJ-2组的苗高、根长均高于对照组,其中GDJ-2组的苗高和根长分别达到10.69 cm、9.24 cm,较对照组分别增长了20.14%、30.56%。上述结果表明,两种自生固氮菌均可促进黑麦草种子的萌发和生长。
表 3结果显示,施用GDJ-1、GDJ-2菌液的处理组较对照组的黑麦草株高分别增长了14.85%、27.72%,地上鲜物质量较对照组分别增加了29.09%、35.71%,地上干物质量较对照组分别增加了5.05%、4.93%,地下鲜物质量较对照组分别增加了13.40%、46.38%,地下干物质量较对照组分别增加了16.40%、44.30%。可见,GDJ-1与GDJ-2均可促进黑麦草的生长,且GDJ-2对地下部分的提升更明显。
|
|
表 3 自生固氮菌GDJ-1与GDJ-2对黑麦草生长的影响 Table 3 Effects of autotrophic nitrogen-fixing bacteria GDJ-1 and GDJ-2 on the growth of ryegrass |
施用GDJ-1与GDJ-2菌液后,植被混凝土中全氮与碱解氮含量均呈上升趋势(表 2)。这是由于施用菌液后,土壤中固氮微生物增多并占据一定的生态位,促进了土壤中的氮素循环,使土壤中氮素供应更加充分[18]。此外,固氮微生物的引入会引起土壤中微生物群落结构重组,其中对依赖氮素生长的微生物种群的影响尤为明显[19]。例如,土壤中的纤维素分解菌就与固氮菌之间存在着互利共生关系[20]。纤维素分解菌通过降解纤维素产生糖类和有机酸,为固氮菌提供必要的碳源和能源,而固氮菌则通过固氮作用向纤维素分解菌回馈氮素营养[21]。GDJ-1与GDJ-2的引入可能与其他微生物如纤维分解菌产生协同作用,促使植被混凝土微生物群落结构调整,加速营养元素的转化过程。
微生物的产酸能力会影响土壤酸碱环境,如陈树莓等[22]在盆栽中加入CSM-129菌液后土壤的pH从4.32下降至3.68。本研究中,施用两种菌液后植被混凝土pH呈下降趋势(表 2),表明GDJ-1与GDJ-2一定程度上可中和植被混凝土碱性环境,利于植物生长。植被混凝土pH还与有效磷含量呈现显著负相关关系(P < 0.05)(图 7a),这是由于GDJ-1与GDJ-2通过降低植被混凝土的pH间接影响磷的有效性。该影响可从两方面解析:一方面,自生固氮菌在增殖过程中可能释放氢离子以及有机酸如草酸和柠檬酸[23],这些酸性物质能促进土壤中难溶性磷化合物的溶解;另一方面,这些有机酸能够与土壤中的钙、铁、铝等金属离子形成螯合物,减少金属离子与磷酸根离子的结合,从而提高可溶性磷酸盐含量[24]。此外,植被混凝土有机质含量与全氮、碱解氮、有效磷及速效钾含量之间均呈正相关关系(图 7a)。这是由于有机质作为土壤中氮、磷、钾等重要元素的主要载体,在微生物作用下逐步分解转化为植物易于吸收的无机形态,从而增加了土壤中有效氮、磷、钾的含量[25]。
3.2 施用GDJ-1与GDJ-2菌液对黑麦草生长的影响固氮菌具有植物促生作用,如曹晶晶等[26]分离的DJ-1自生固氮菌可使玉米株高、地上与地下干物质量分别提升26.01%、86.5%、74.37%。本研究分离的自生固氮菌对黑麦草株高、地上干物质量、地下干物质量的提升范围分别为14.85~27.72%、4.93~5.05%、16.40~44.30%(表 3),提升效果虽不及DJ-1菌株,但依然显示出显著的促生效果。施用GDJ-1与GDJ-2菌液后,黑麦草种子的发芽率与发芽势、苗高与根长均得到提高(图 7b)。这是由于自生固氮菌GDJ-1与GDJ-2将氮气转化为种子可吸收的氮素形态,在种子萌发初期提供必要的氮素营养,促进种子的内部代谢活动和萌发所需酶的合成[27]。此外,GDJ-1与GDJ-2分泌的代谢产物可能包含植物激素,这类植物激素包括吲哚乙酸(IAA)、类细胞分裂素(CTK)及类赤霉素(GA)等[28],可直接刺激种子的发芽过程,促进胚胎突破种皮和生长[29]。
值得注意的是,尽管GDJ-1组的有机质、全氮、碱解氮、有效磷、速效钾等均高于GDJ-2组(表 2),但黑麦草的长势包括株高、地上生物量、地下生物量却低于GDJ-2组(表 3),该现象与土壤养分丰富会促进植物生长更旺盛的一般规律有所不同。这可能是由于GDJ-1与GDJ-2在植被混凝土中发挥的促生长功能有差异。首先,施用GDJ-2菌液的黑麦草种子发芽率和苗高、根长均大于GDJ-1(图 7b),表明自生固氮菌GDJ-2在分泌植物激素促进种子萌发及初期生长方面较GDJ-1更有效。其次,GDJ-2在pH为7~9环境中的生长量高于GDJ-1(图 6a),对于植被混凝土的弱碱性环境GDJ-2具有更优越的适应性,这种耐受性优势导致GDJ-2在该环境下展现出更高产酶活性及激素分泌水平[30],进一步强化了GDJ-2菌株在促进植物生长方面的优势。
3.3 GDJ-1与GDJ-2在植被混凝土生态修复工程中的应用前景冻融区裸露边坡生态修复工程的一大挑战就在于冻融作用会导致微生物的休眠或死亡,活性显著下降,从而抑制土壤中养分循环与转化过程[31]。而GDJ-1与GDJ-2在冻融作用下,仍能保持较高的固氮活性,显示出良好的耐冻融性(图 2),表明两种自生固氮菌在冻融区能维持正常的生理功能。此外,GDJ-1与GDJ-2均为植被混凝土原生环境中分离筛选出的土著固氮菌,相比于外源菌种,在植被混凝土的特定环境中有显著的生存优势,有利于构建稳定的微生物群落结构[32]。
值得一提的是,GDJ-1与GDJ-2因其自身不同的特性在植被混凝土生态修复工程中的适用场景有差别(图 8)。GDJ-1具有较强的固氮作用,能够有效转化土壤中的养分,适合施用于土壤贫瘠或养分缺乏的地区。GDJ-2的环境适应性较好,尤其对碱性环境有更高的耐受性,因此适合应用于盐碱地这类环境较为苛刻的区域。虽然GDJ-1与GDJ-2菌液具有固氮效应和植物促生长作用,但将其制成菌肥或菌剂应用至实际工程过程中仍需考量诸多要素。这包括选取合适的载体介质、精准控制发酵条件至最佳参数,如温度、湿度和pH等[33]。此外,在实际工程应用中应充分考量自生固氮菌的特异性功能,特别是除固氮性能之外的养分活化能力。如魏志敏等[34]分离的N3芽孢杆菌在施用后,土壤速效钾含量提升了21.35%。而本研究中自生固氮菌GDJ-1与GDJ-2均展现出一定解磷能力,但解钾能力较弱(表 2)。考虑到实际工程中养分均衡的需求,后续还可对冻融耐受性好的自生解磷菌、解钾菌、纤维素分解菌等开展研究,制备出适用于冻融区域植被混凝土生态修复的复合菌剂。

|
注:IAA:吲哚乙酸;CTK:类细胞分裂素;GA:类赤霉素。 Note: IAA: Indoleacetic acid; CTK: Cytokinin; GA: Gibberellin. 图 8 自生固氮菌GDJ-1与GDJ-2的作用机理及应用效果分析 Fig. 8 Analysis of the mechanism and application effect of autotrophic nitrogen-fixing bacteria GDJ-1 and GDJ-2 |
从植被混凝土中分离出两株冻融耐受性较好的自生固氮菌GDJ-1与GDJ-2,并对其开展形态学特征、生理生化特征、16S rDNA、系统发育分析,分别鉴定为蛋白水解微杆菌(Microbacterium proteolyticum)和皮氏罗尔斯顿菌(Ralstonia pickettii)。GDJ-1与GDJ-2均可发挥固氮作用,增加植被混凝土中全氮、碱解氮含量,并具备一定解磷功能。施用GDJ-1菌液后植被混凝土的碱解氮和有效磷含量高于GDJ-2,GDJ-2则对黑麦草生长有更显著作用。因此,在不同应用场景下,两种自生固氮菌各有优势。为更好地实现功能性微生物在环境修复中的功效,在本研究的两种自生固氮菌基础上,后续还可进一步对其他类型功能微生物开展研究,通过制备复合菌剂综合提升冻融地区裸露边坡植被混凝土生态修复效果。
| [1] |
Zhao B Q, Xia Z Y, Xu W N, et al. Review on research of slope eco-restoration technique for engineering disturbed area (In Chinese)[J]. Water Resources and Hydropower Engineering, 2017, 48(2): 130-137. [赵冰琴, 夏振尧, 许文年, 等. 工程扰动区边坡生态修复技术研究综述[J]. 水利水电技术, 2017, 48(2): 130-137.]
(  0) 0) |
| [2] |
Liu L M, Song Y S, Zhong B, et al. Research progress on ecological restoration technology of vegetation concrete (In Chinese)[J]. Journal of Environmental Engineering Technology, 2022, 12(3): 916-927. [刘黎明, 宋岩松, 钟斌, 等. 植被混凝土生态修复技术研究进展[J]. 环境工程技术学报, 2022, 12(3): 916-927.]
(  0) 0) |
| [3] |
Yang Y S, Chen J S, Zhou T L, et al. Effects of freeze-thaw cycling on the engineering properties of vegetation concrete[J]. Journal of Environmental Management, 2023, 345: 118810. DOI:10.1016/j.jenvman.2023.118810
(  0) 0) |
| [4] |
Liu J, Chen X F, Liu M, et al. Effects of long-term fertilization on bacterial community in upland red soil (In Chinese)[J]. Acta Pedologica Sinica, 2020, 57(2): 468-478. DOI:10.11766/trxb201810090507 [刘佳, 陈晓芬, 刘明, 等. 长期施肥对旱地红壤细菌群落的影响[J]. 土壤学报, 2020, 57(2): 468-478.]
(  0) 0) |
| [5] |
Shi H M, Lu L X, Ye J R, et al. Effects of two Bacillus velezensis microbial inoculants on the growth and rhizosphere soil environment of Prunus davidiana[J]. International Journal of Molecular Sciences, 2022, 23(21): 13639. DOI:10.3390/ijms232113639
(  0) 0) |
| [6] |
Bhat T, Ahmad M L, Ganai A, et al. Nitrogen fixing biofertilizers; mechanism and growth promotion: A review[J]. Journal of Pure and Applied Microbiology, 2015, 9(2): 1675-1690.
(  0) 0) |
| [7] |
Jiang L Y, Pettitt T R, Buenfeld N, et al. A critical review of the physiological, ecological, physical and chemical factors influencing the microbial degradation of concrete by fungi[J]. Building and Environment, 2022, 214: 108925. DOI:10.1016/j.buildenv.2022.108925
(  0) 0) |
| [8] |
Duan Y N, Liu E T, Chen X S, et al. Effects of freezing-thawing on soil microbial quantities and enzymatic activities of old apple orchards (In Chinese)[J]. Soils, 2021, 53(1): 125-132. [段亚楠, 刘恩太, 陈学森, 等. 冻融对老龄苹果园土壤微生物数量及酶活性的影响[J]. 土壤, 2021, 53(1): 125-132.]
(  0) 0) |
| [9] |
Juan Y H, Jiang N, Tian L L, et al. Effect of freeze-thaw on a midtemperate soil bacterial community and the correlation network of its members[J]. BioMed Research International, 2018, 2018: 8412429.
(  0) 0) |
| [10] |
Miura M, Jones T G, Hill P W, et al. Freeze-thaw and dry-wet events reduce microbial extracellular enzyme activity, but not organic matter turnover in an agricultural grassland soil[J]. Applied Soil Ecology, 2019, 144: 196-199. DOI:10.1016/j.apsoil.2019.08.002
(  0) 0) |
| [11] |
National Energy Bureau of the People's Republic of China. Technical code for eco-restoration of vegetation concrete on steep slope of hydropower projects: NB/T 35082—2016[S]. Beijing: China Water & Power Press, 2016.[国家能源局. 水电工程陡边坡植被混凝土生态修复技术规范: NB/T 35082—2016[S]. 北京: 中国水利水电出版社, 2016.]
(  0) 0) |
| [12] |
Dong X Z, Cai M Y. Handbook of identification of common bacterial systems (In Chinese). Beijing: Science Press, 2001. [东秀珠, 蔡妙英. 常见细菌系统鉴定手册[M]. 北京: 科学出版社, 2001.]
(  0) 0) |
| [13] |
Cai X Z, Huang J H. Microbiological experiment (In Chinese). 3rd ed[M]. Beijing: Science Press, 2010. [蔡信之, 黄君红. 微生物学实验[M]. 3版. 北京: 科学出版社, 2010.]
(  0) 0) |
| [14] |
Alves A, Riesco R, Correia A, et al. Microbacterium proteolyticum sp. nov. isolated from roots of Halimione portulacoides[J]. International Journal of Systematic and Evolutionary Microbiology, 2015, 65(6): 1794-1798.
(  0) 0) |
| [15] |
Nasir N, Sayeed M A, Jamil B. Ralstonia pickettii bacteremia: An emerging infection in a tertiary care hospital setting[J]. Cureus, 2019, 11(7): e5084.
(  0) 0) |
| [16] |
Yuan C, An T F, Li X L, et al. Genomic analysis of Ralstonia pickettii reveals the genetic features for potential pathogenicity and adaptive evolution in drinking water[J]. Frontiers in Microbiology, 2024, 14: 1272636. DOI:10.3389/fmicb.2023.1272636
(  0) 0) |
| [17] |
Nabilah B, Purnomo A S, Prasetyoko D, et al. Methylene Blue biodecolorization and biodegradation by immobilized mixed cultures of Trichoderma viride and Ralstonia pickettii into SA-PVA-Bentonite matrix[J]. Arabian Journal of Chemistry, 2023, 16(8): 104940. DOI:10.1016/j.arabjc.2023.104940
(  0) 0) |
| [18] |
Gou Z C, Zheng H Y, He Z Q, et al. The combined action of biochar and nitrogen-fixing bacteria on microbial and enzymatic activities of soil N cycling[J]. Environmental Pollution, 2023, 317: 120790. DOI:10.1016/j.envpol.2022.120790
(  0) 0) |
| [19] |
Liu J Y, Wei Y, Du H T, et al. Effects of intercropping between Morus alba and nitrogen fixing species on soil microbial community structure and diversity[J]. Forests, 2022, 13(9): 1345. DOI:10.3390/f13091345
(  0) 0) |
| [20] |
Shinde R, Shahi D K, Mahapatra P, et al. Potential of lignocellulose degrading microorganisms for agricultural residue decomposition in soil: A review[J]. Journal of Environmental Management, 2022, 320: 115843. DOI:10.1016/j.jenvman.2022.115843
(  0) 0) |
| [21] |
Harindintwali J D, Zhou J L, Muhoza B, et al. Integrated eco-strategies towards sustainable carbon and nitrogen cycling in agriculture[J]. Journal of Environmental Management, 2021, 293: 112856. DOI:10.1016/j.jenvman.2021.112856
(  0) 0) |
| [22] |
Chen S M, Yu Z J, Shi X Q, et al. Bacteria isolated from rhizosphere soils of three blueberry varieties affect the growth and development of blueberry seedlings (In Chinese)[J]. Acta Microbiologica Sinica, 2024, 64(2): 565-580. [陈树莓, 俞正杰, 时潇琼, 等. 三种蓝莓根际细菌的分离及其对蓝莓苗生长发育的影响[J]. 微生物学报, 2024, 64(2): 565-580.]
(  0) 0) |
| [23] |
Wagh J, Bhandari P, Shah S, et al. Overexpression of citrate operon in Herbaspirillum seropedicae Z67 enhances organic acid secretion, mineral phosphate solubilization and growth promotion of Oryza sativa[J]. Plant and Soil, 2014, 383(1): 73-86. DOI:10.1007/s11104-014-2161-2
(  0) 0) |
| [24] |
Jiang R H, Wen S F, Zhu C Q, et al. Research on the promotion of maize growth and immobilization of Pb in the rhizosphere by Pb-tolerant phosphate solubilizing bacteria in Pb-contaminated mining areas (In Chinese)[J]. Ecology and Environmental Sciences, 2024, 33(2): 291-300. [江润海, 温绍福, 朱城强, 等. 铅污染矿区中耐铅解磷菌对玉米的促生及根际铅的固化效应[J]. 生态环境学报, 2024, 33(2): 291-300.]
(  0) 0) |
| [25] |
Wang J K, Xu Y D, Ding F, et al. Process of plant residue transforming into soil organic matter and mechanism of its stabilization: A review (In Chinese)[J]. Acta Pedologica Sinica, 2019, 56(3): 528-540. DOI:10.11766/trxb201811140559 [汪景宽, 徐英德, 丁凡, 等. 植物残体向土壤有机质转化过程及其稳定机制的研究进展[J]. 土壤学报, 2019, 56(3): 528-540.]
(  0) 0) |
| [26] |
Cao J J, Xiong M Z, Chao Y P, et al. Isolation and identification of extremely salt-tolerant azotobacter and its nitrogen-fixing characteristics (In Chinese)[J]. Acta Microbiologica Sinica, 2021, 61(11): 3483-3495. [曹晶晶, 熊悯梓, 钞亚鹏, 等. 极耐盐碱固氮菌的分离鉴定及固氮特性研究[J]. 微生物学报, 2021, 61(11): 3483-3495.]
(  0) 0) |
| [27] |
Puri A, Padda K P, Chanway C P. Nitrogen-fixation by endophytic bacteria in agricultural crops: Recent advances[M]//Nitrogen in agriculture - Updates. London, GBR: InTechOpen, 2018: 73—94.
(  0) 0) |
| [28] |
Eid A M, Fouda A, Abdel-Rahman M A, et al. Harnessing bacterial endophytes for promotion of plant growth and biotechnological applications: An overview[J]. Plants, 2021, 10(5): 935. DOI:10.3390/plants10050935
(  0) 0) |
| [29] |
Woźniak M, Gałązka A, Tyśkiewicz R, et al. Endophytic bacteria potentially promote plant growth by synthesizing different metabolites and their phenotypic/physiological profiles in the biolog GEN Ⅲ MicroPlateTM test[J]. International Journal of Molecular Sciences, 2019, 20(21): 5283. DOI:10.3390/ijms20215283
(  0) 0) |
| [30] |
Saleem M, Nawaz F, Hussain M B, et al. Comparative effects of individual and consortia plant growth promoting bacteria on physiological and enzymatic mechanisms to confer drought tolerance in maize (Zea mays L.)[J]. Journal of Soil Science and Plant Nutrition, 2021, 21(4): 3461-3476. DOI:10.1007/s42729-021-00620-y
(  0) 0) |
| [31] |
Ji X M, Liu M H, Yang J L, et al. Meta-analysis of the impact of freeze–thaw cycles on soil microbial diversity and C and N dynamics[J]. Soil Biology and Biochemistry, 2022, 168: 108608. DOI:10.1016/j.soilbio.2022.108608
(  0) 0) |
| [32] |
Mawarda P C, Le Roux X, van Elsas J D, et al. Deliberate introduction of invisible invaders: A critical appraisal of the impact of microbial inoculants on soil microbial communities[J]. Soil Biology and Biochemistry, 2020, 148: 107874. DOI:10.1016/j.soilbio.2020.107874
(  0) 0) |
| [33] |
Vassileva M, Malusà E, Sas-Paszt L, et al. Fermentation strategies to improve soil bio-inoculant production and quality[J]. Microorganisms, 2021, 9(6): 1254. DOI:10.3390/microorganisms9061254
(  0) 0) |
| [34] |
Wei Z M, Sun B, Fang C, et al. Isolation and characterization of Bacillus nitrogen-fixing bacteria and its growth-promotion on Orychophragmus violaceus (In Chinese)[J]. Soils, 2021, 53(1): 64-71. [魏志敏, 孙斌, 方成, 等. 固氮芽孢杆菌N3的筛选鉴定及其对二月兰的促生效果[J]. 土壤, 2021, 53(1): 64-71.]
(  0) 0) |
 2025, Vol. 62
2025, Vol. 62


